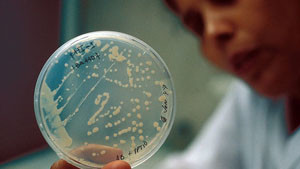
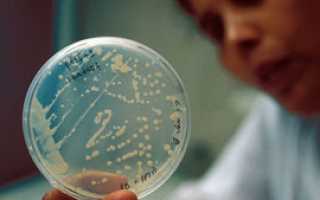

Температура при отравлении – это симптом развития негативных процессов в организме, связанных с приемом некачественных продуктов, напитков, еды и вредных веществ. Она может появляться на различных стадиях интоксикации.
Распространенные признаки отравления
Отравление могут вызвать:
- медикаменты;
- алкогольная продукция;
- угарный газ;
- ядохимикаты.
Несмотря на наличие бактерий в организме при отравлении, оно не является заразным. Симптомы недуга:
- тошнота, рвота;
- понос;
- слабость и головокружение;
- высокая температура и озноб.
В каких случаях может появиться высокая температура
При самом распространенном — пищевом отравлении, в организм человека вместе с едой попадают микроорганизмы (кишечные палочки, стафилококки, сальмонеллы и другие токсины) или вирусная инфекция. Иммунитет начинает с ними бороться, и температура поднимается что является первым признаком интоксикации. Зачастую болит живот, наблюдается диарея, расстройство желудка и сухость во рту.
Расщепление алкоголя в крови вызывает выброс свободных радикалов и токсинов, что приводит к отравлению, известному как похмелье. Симптомы:
- головная боль;
- слабость;
- пониженное давление;
- обезвоживание.
Нередким случаем является отравление химическими веществами, входящими в препараты для химиотерапии. Помимо данной реакции на данную процедуру, могут быть отмечены:
- нарушение стула (запоры);
- зуд и отечность кожи;
- слабость.
Отравление угарным газом сопровождается показателем в 38-39 градусов, лишь при его тяжелом течении. У человека возникают необратимые поражения мозговой ткани, что может привести к летальному исходу. Лихорадка может проявиться через 2-3 дня после острого отравления, как последствие, ухудшение координации, головокружения, головные боли и другие нарушения центральной нервной системы.
Может ли появиться низкая температура
Низкая температура тела или гипотермия, возникает по причине нарушения терморегуляции тела, что вызывается попаданием в организм бактерий или токсичных веществ. При отравлении алкоголем, лекарственными препаратами, ядовитыми и химическими веществами, отметка может падать ниже 35 градусов.
Данное состояние сопровождается дрожью и морозностью конечностей, бледностью кожи, слабостью и мышечными болями. При пониженной температуре необходимо согреть больного (можно растереть его теплым полотенцем или сделать легкий массаж) и дать выпить горячий чай с медом.
Снять неприятные симптомы и повысить показатель помогут народные методы:
- Натереть солью область подмышек.
- Попарить ноги в теплой воде с горчицей.
- Съесть кубик сахара с несколькими капельками йода (4-5 капель).
Связь температуры с тяжестью отравления
Температура 37.0 при интоксикации не представляет опасности и ее не нужно сбивать. Возникает при легких формах отравления и проходит по мере вывода токсинов из организма.
Если температура держится в течение нескольких дней и после того, как прошли другие симптомы, это значит, что организм продолжает выводить вредные вещества и необходимо продолжить лечение. Нужно соблюдать щадящую диеты (каши, овощи, рис, супы), пить много воды и принимать сорбенты для ускорения очищения.
Температура 38 градусов указывает на отравление средней тяжести. Чтобы не допустить ее повышения, нужно:
- обратиться к врачу;
- сделать промывание желудка;
- поставить клизму для скорейшего вывода токсинов;
- принять сорбент.
Такая температура сопровождается ознобом, понижением артериального давления, слабостью, судорогами. Больному нужно пить много жидкости и дать жаропонижающее средство. Рекомендуется сделать обтирание слабым раствором спирта и примочки из капустного листа.
Как сбить температуру у детей и взрослых
Сбивать можно только при ее повышении более 38 градусов. Несмотря на то, что таблетки являются крайней мерой, и дают нагрузку на почки и печень, это наиболее быстрый способ снизить температуру. Лекарства обладают жаропонижающим и противовоспалительным действием. Популярные аптечные средства для взрослых:
Если при отравлении наблюдается рвота, принимать пероральные медикаменты не стоит. Понизить температуру помогут суппозитории (Нурофен, Вибуркол) и растворимы таблетки и порошки (Эффералган, Нимесил, Нимулид).
При повышении до 39.2 градусов, эффективно ее сбить получится при помощи введения жаропонижающих инъекций: 2 мл анальгина и 2 мл димедрола внутримышечно.
Для снижения температуры у беременных женщин не рекомендуется принимать многие жароснижающие препараты и антибиотики, они могут спровоцировать кровотечения и аномалии плода. Среди лекарств могут быть использованы средства на основе парацетамола (Парацетамол, Панадол, Тайленол).
Если гипертермия у ребенка, необходимо проветрить комнату, обеспечить обильное питье и дать жаропонижающее средство — парацетамол (можно давать детям с 3 месяцев). Ребенка, находящегося на грудном вскармливании, необходимо чаще прикладывать к груди для поступления в его организм достаточного количества влаги.
В народной медицине есть немало рецептов, способствующих лечить гипертермию в домашних условиях у взрослых и у беременных и детей:
- отлично снимает жар липовый отвар;
- малиновый настой или чай;
- компрессы из картофеля и яблочного уксуса;
- растирание столовым уксусом (область коленных и локтевых сгибов, лоб, шея, виски).
По отзывам известного педиатра — доктора Комаровского, не рекомендует проводить обтирания ребенка уксусом и спиртовым раствором. Ввиду слабой иммунной системы, это может вызвать дополнительное отравление организма.
Сколько держится температура после отравления
Сколько будет держаться температура после отравления, зависит от корректности лечения и сложности интоксикации. Обычно, она наблюдается на время выхода токсина из организма, что длится 2-3 дня. При сильных формах и неправильном лечении, может не спадать долго — около недели, что является поводом для обращения за медицинской помощью.
Профилактика появления
Каждый знает, что отравление с температурой протекает сложно. И лучший способ избежать появления лихорадки — соблюдать правила профилактики:
- не употреблять некачественные и испорченные продукты и медикаменты;
- при работе с хим. веществами носить марлевую повязку;
- соблюдать норму в потреблении алкоголя;
- чаще мыть руки.
Если уже отравились, необходимо промыть желудок, лечь в хорошо проветриваемом помещении и пить много воды.
Температура сопровождает многие формы и степени отравления и может привести к печальным последствиям. В ожидании врачебной помощи, важно знать методы ее устранения, чтобы не допустить осложнений. В тяжелых случаях отравления на счету может быть каждая минута человеческой жизни.

Бывает ли температура при пищевом отравлении и насколько это опасно? Какие меры предпринять в подобном случае? Прежде чем узнать, что делать при пищевом отравлении с температурой, давайте разберёмся, какие процессы происходят при интоксикации в организме.
Почему повышается температура при отравлении
Отравление пищей с температурой довольно распространённое заболевание. Очень часто одним из признаков употребления опасных для здоровья продуктов становится повышение температуры. Ведь лихорадка – это великолепный защитный механизм, выработанный природой против болезнетворных микробов и вредных веществ. При повышении температуры тела ускоряется обмен веществ, улучшается кровообращение и микроциркуляция жидкости в тканях и органах, ускоряется распад и выведение токсинов из организма. Усиливается потоотделение, расширяются сосуды кожи, что также облегчает выведение шлаков. При повышении температуры внутренняя среда становится неблагоприятной для большинства болезнетворных бактерий.
По своему виду отравления разделяются на:
микробные — токсикоинфекции, токсикозы;
- немикробные — ядами растительного и животного происхождения;
- а также интоксикации примесями химических веществ.
Существует около 30 потенциально опасных бактерий, среди которых всем известные возбудители дизентерии, колибактериоза, сальмонеллеза, ботулизма и холеры, которые могут вызвать микробное отравление.
Другой причиной, почему повышается температура при пищевом отравлении, является нарушение баланса кишечной микрофлоры. В кишечнике ослабляются полезные бактерии и активизируются условно-вредные, в частности, кокковые формы. В любом случае организм реагирует на такие факторы лихорадкой. Поэтому отличить инфекционное отравление от неинфекционного по характеру изменения температуры тела на практике невозможно.
В каких случаях опасна температура
Любое пищевое отравление с температурой требует немедленного обращения к врачу, в случаях, если:
- развивается сильная многократная рвота;
- появляется жидкий стул более 10 раз в сутки или с примесью крови;
- при сильном обезвоживании;
- при первых признаках поражения нервной системы: мышечной дрожи, судорогах, изменении дыхания, расстройствах сознания, сужении или расширении зрачков;
- если после оказания мер первой помощи температура остаётся высокой, не сбивается лекарствами или понижается ненадолго.
Даже при обычном отравлении испорченными продуктами температура тела может повышаться до 40 °C. Опасно, если она поднимается выше 38,5 °C или держится более суток.
Лечение отравления с температурой
Врачи не рекомендуют использовать какие-либо жаропонижающие средства, если градусник показывает не больше 38,5 °C. Ведь в этом случае высокая температура – помощник, а не источник опасности.
Пищевое отравление до 38 °C лечится по общей схеме. После облегчения состояния организма этот показатель приходит в норму в течение первых суток.
Рассмотрим подробно, чем лечить пищевое отравление с температурой.
- Промывание желудка большим количеством подсоленной воды или слабо-розовым раствором марганцовки.
- Приём адсорбентов – активированный уголь из расчёта 1 таблетка на 10 кг веса, Энтеросгель, Полисорб МП и другие препараты.
- Слабительное – 30 грамм сульфата магния или натрия в 400 мл воды.
- Очистительная клизма с физраствором или отваром ромашки, календулы.
- Обильное питье – кипячёная вода, отвар трав (ромашка, календула, зверобой). При этом учитывают, что на каждый градус повышения температуры необходимо выпивать лишний литр жидкости.
Также не рекомендуют останавливать понос с помощью закрепляющих препаратов — это помешает выведению токсических веществ из организма. Первые сутки после пищевого отравления с температурой в качестве лечения применяют голодную диету. На второй день употребляют щадящую пищу – жидкие каши, картофельное пюре, яйцо вкрутую.
Температура при пищевом отравлении у ребёнка
Температура при пищевом отравлении у ребёнка представляет более серьёзную проблему, чем у взрослых. Необходимо точно установить причину заболевания, для чего следует обратиться к врачу. Обязательно получение квалифицированной помощи и в том случае, если возраст пострадавшего малыша менее трёх лет. Малыши тяжелее переносят отравления, у них быстро развивается обезвоживание, которое тяжелее восполнить в домашних условиях.
Как лечить пищевое отравление с температурой у детей? Ориентируются на следующие рекомендации врачей.
- Не сбивать если она ниже 38,5 °C. Это правило не относится к тем детям, у кого есть хронические заболевания, склонность к судорогам или признаки ухудшения состояния: сильный озноб, боли в мышцах и суставах, бледность.
- Для снижения температуры тела в первую очередь применяют обтирание. Детей младше трёхлетнего возраста обтирают полотенцем или салфеткой, смоченной в воде комнатной температуры. Для более старших используют раствор столового 9% уксуса в разведении с водой 1:1. Обтирают руки, ноги, шею, грудь, лицо. Влажную салфетку кладут ребёнку на лоб.
- При использовании лекарственных препаратов дозу согласуют с лечащим врачом, так как ослабленный токсинами организм будет реагировать на жаропонижающее по-другому. Назначают таблетки или ректальные свечи на основе парацетамола или ибупрофена. Не рекомендуется давать жаропонижающие сиропы и порошки, так как в них содержатся балластные вещества: красители, ароматизаторы и тому подобное, что при повышенной чувствительности желудка и кишечника нежелательно.
Детям нельзя применять жаропонижающие средства из группы Аспирина, Анальгина и Амидопирина — у этих препаратов много побочных эффектов.
- Повторно принимать жаропонижающие препараты можно только через 5–6 часов. Если эффекта от их употребления нет, вызывают скорую помощь.
- Для восполнения потери жидкости дают обильное питье: кипячёная вода (на 1 литр добавляют 3 столовые ложки сахара и 1 чайную ложку соли). Или применяют аптечные растворы: Регидрон и другие.
- Очистительную клизму для детей делают с крахмальным киселём.
Необходимо знать, что у ребёнка до года температура до 37,4 °C считается нормальной. И в любом возрасте показания градусника во рту, будет на полградуса выше, чем в подмышечной впадине.
В любом случае при первых признаках отравления – тошнота, рвота, понос, нужно принять меры по оказанию первой помощи. Для этого промывают желудок, принимают активированный уголь или другие адсорбенты, применяют слабительное. При повышении температуры тела до 38,5 °C не стоит волноваться – так организм борется с токсинами. В этом случае жаропонижающие средства не используют. А вот если температура высокая или не снижается в течение суток, то следует обратиться за медицинской помощью.

Сигналом тревоги отравления могут служить чувство слабости, диарея, тошнота, рвота, болезненные спазмы. Температура при отравлении считается неплохим признаком, так как является нормальным защитным механизмом организма. Иммунная система пытается таким образом убить вредоносные токсины и бактерии при отравлении.
Что делать при отравлении с температурой?
Чтобы сбить температуру при отравлении можно провести ряд мероприятий. Больного следует уложить в постель, но при этом не нужно укутывать его в тёплое одеяло. Давать ему больше жидкости, соков, морса, насыщенных витаминами. Хорошо помогает обтирание разбавленным с водой уксусным раствором или водкой. Можно приложить больному на лоб холодный компресс. Пострадавшему следует придерживаться диеты.
При отравлении с температурой нужно проконсультироваться с врачом о проведении домашнего лечения. Он порекомендует, что пить при отравлении с температурой. Народная медицина предлагает эффективный отвар из липового чая.
Для его приготовления возьмите сушёные листья растения, залейте кипячёной водой и оставьте настояться около пяти минут. Затем процеженную жидкость наполовину смешайте с прохладной водой. Отвар готов к приёму. Пить его следует часто и даже можно давать ребенку с 4 лет.
Чай можно приготовить таким методом из ивовых прутьев. Он не только принесёт гипертермальный эффект, но также нормализует микрофлору.
Повышение температуры тела при отравлении вызывают пирогены. На их появление влияет активность иммунных клеток или жизнедеятельность вирусных агентов, которые способны вызвать сбой в мозговом центре терморегуляции центральной нервной системе.
На появление гипертермии могут влиять разные факторы:
- попадание во время еды вредных микробов вместе с грязными фруктами, овощами;
- содержание огромного количества в них пестицидов, нитратов;
- инфицированное мясо;
- во время приготовления не была выдержана нужная термическая обработка;
- неправильное хранение продуктов питания в холодильнике;
- употребление ядовитых грибов;
- приём съедобных грибов с увеличенным количеством токсин с экологически загрязнённых территорий;
- попадание стафилококков и сальмонеллы с молоком;
- длительное хранение консервации в домашних условиях.
Мысль о том, как можно сбить повышенную температуру при отравлении, какие можно пить лекарства, посещает многих. Однако врачи не советуют принимать жаропонижающие препараты при отравлении температурой, если столбик термометра не поднимается выше 37.4–37.9 градусов. Поскольку гипертермия помогает уничтожить инфекцию, не стоит спешить сбивать её. Система способна самостоятельно регулировать все процессы, которые проходят в нём.
Если же показание градусов достигает отметки 39.4, у больного могут образовываться опасные осложнения. В таких случаях рекомендуется принять целебные средства, способные снизить симптомы отравления с температурой:
Рекомендуется употреблять, но только по назначению доктора, антибиотики: Цефикс, Нифуроксазид, Фуразолидон.
Ребенка нельзя вылечить теми же медикаментами, что и взрослого. Для них подойдут следующие рекомендации:
- облюдать постельный режим;
- проветривать помещение, в котором находится больной;
- больше употреблять щелочной минеральной воды, так как много жидкости теряется в процессе извержения желудка, поноса.
Если у грудного ребёнка субфебрильная горячка в пределах 37.0, 37.2, 37.3 градусов, можно воспользоваться физическими методами. Оботрите малыша холодной водой, разденьте его и прикройте лёгкой простынкой.
При больших показателях градусника нужно переходить на медикаментозную терапию, которую назначает педиатр. В зависимости от того, сколько держится увеличенная температура при отравлении, подбирается правильный метод терапии. Родители должны помнить, что детям категорически запрещено давать ацетилсалициловую кислоту. Аспирин может привести к острому геморрагическому синдрому, который приводит к летальному исходу.
Почему повышается температура при отравлении?
В условиях нарушения кишечной микрофлоры, активно идёт развитие кокковых бактерий, попадающих с испорченной едой. Вследствие этого развивается классическая симптоматика: начинает больного тошнить, появляется блевота, понос. Если вовремя не провести очищение желудка и кишечника, бактерии продолжат размножаться.
Чтобы избавиться от них и создать для этих патогенных микробов неблагоприятную среду, начинает взлетать ртутный столбик градусника. Благодаря гипертермии ускоряется процесс метаболизма и синтеза белковых молекул. Эти манипуляции необходимы для выведения вредных агентов и скорого выздоровления.
Если при недомогании градусник показывает свыше 38.5 градусов и держится больше суток, появляется надобность в медицинской помощи. Особенно это может быть опасным для тех, кто болеет серьёзными хроническими заболеваниями.
При гипертермии нарушаются функции практически всех систем человека:
- сердечной: сосудистый спазм повышает артериальное давление, болит голова;
- дыхательной: больной начинает дышать часто, но неглубоко;
- пищеварительной: пропадает аппетит, сухость во рту, идёт развитие спастических и атонических запоров;
- появляется усиленный диурез, что приводит к пониженному образованию мочи и накопление натрия, увеличению содержания хлора;
- развивается гиповитаминоз, так как теряются витамины и провитамины;
- страдает нервная система: больной жалуется на головную боль, сонливость, усталость, ломоту.
При любом проявлении пищевого отравления следует вызвать неотложную помощь.
Рассматривая вопрос, бывает ли температура при отравлении, видно, что ответ скорее положителен, но очень индивидуален. Поэтому, чтобы помочь больному, следует терапию назначать исходя из личных особенностей человека, степени тяжести отравления с температурой.
При температуре 38.2–38.3° терапия происходит по общепринятой схеме. При правильно проведённых процедурах состояние больного нормализуется в течение суток.
Для начала пострадавшему промывают желудок слабым раствором марганцовки или большим количеством подсоленной воды, затем вызывают искусственный отхаркивающий рефлекс. Следует повторять манипуляцию несколько раз. Больному дают адсорбенты, такие как:
- таблетки активированного угля;
- Энтеросгель;
- Полисорб и другие энтерсорбенты.
Очиститься от вредоносных токсинов поможет приём слабительного из сульфата магния и проведение клизмы. Процедуру проделывают с помощью физраствора или отвара целебной ромашки, календулы.
Следует давать пострадавшему как можно больше пить. Это могут быть отвары из ромашки, зверобоя, а также чистая кипячёная вода, чаи.
Нельзя давать закрепляющие медикаменты, так как они мешают выведению токсических веществ. Восстановить кислотно-щелочное равновесие поможет приём Регидрона. Он быстро пополняет запасы натрия и калия, потерянные вследствие диареи. Основным этапом восстановления нормального состояния является поддерживание строгого рациона. Можно употреблять каши в жидкой консистенции, картофельное, яблочное пюре, нежирное отварное мясо.
Если своевременно провести детоксикацию, тогда гипертермия может не случиться. Помощь следует оказывать быстро и адекватно, так как от этого зависит дальнейшее здоровье пострадавшего.
Пищевое отравление проявляется разными симптомами: спазмами желудка, тошнотой, рвотой, побледнением кожных покровов (первые признаки отравления). В большинстве случаев температура после отравления поднимается до +37…+37,5 °C и выше. Состояние сопровождается дрожью и ознобом.
Причины гипертермии
Гипертермия — снижение температуры ниже отметки 36 °C. Состояние наблюдается по следующим причинам:
- отравление ядовитыми веществами, токсинами;
- интоксикация вследствие использования трав в лечебных целях;
- распитие некачественных спиртных напитков;
- недостаточное поступление с пищей полезных веществ и витаминов.
При гипертермии возникают такие проявления:
- онемение рук и ног;
- упадок сил;
- сонное состояние;
- головокружение;
- усиленное потоотделение;
- побледнение кожных покровов.
Многих интересует вопрос, сколько держится температура после отравления. На процесс влияет степень интоксикации организма и правильность применяемой терапии. Чаще всего гипертермия длится до 3 дней.
В каких случаях опасно повышение температуры
При заражении организма наблюдается нарушение терморегуляции тела, что вызывается патогенными микроорганизмами и вредными веществами. Гипертермия негативно воздействует на органы и системы организма. Страдает пищеварительная система: при отсутствии аппетита снижается выработка слюны, а недостаточное количество жидкости в организме провоцирует запоры.
Повышение температуры даже на 1 °C учащает пульс и создает увеличенную нагрузку на сердце, а также повышается артериальное давление, возникает спазм сосудов.
При гипертермии нарушается водно-электролитный баланс, что приводит к частому мочеиспусканию.
При повышении температуры дыхание становится неглубоким, организм перестает усваивать в полном объеме питательные вещества и витамины, обменные процессы нарушаются.
Предпосылками к возникновению гипертермии могут стать следующие факторы и патологии:
- Заражение кишечника инфекцией. В кишечник могут проникнуть возбудители заболеваний: ботулизма, дизентерии, холеры, кишечная палочка и сальмонеллез. Бактерии приводят к мощной интоксикации и возникновению воспалительного процесса в кишечнике. Иммунная система начинает активную борьбу с патогенной микрофлорой.
- Острый гастрит. Токсические вещества поражают слизистую и провоцируют воспаление. Появляется гастрит, при котором болит желудок, возникают позывы к рвоте. Температура сохраняется на отметке 37,5 °C.
- Панкреатит. Ядовитые вещества приводят к воспалению поджелудочной железы. Во время острого поражения поджелудочной возникают болевые ощущения в области живота, а температура может повыситься до 39,5 °C. Пациента нужно срочно госпитализировать.
- Обезвоживание организма после длительной рвоты или диареи. Ощущается упадок сил, кожа приобретает бледный оттенок и теряет тонус, глазные яблоки западают.
Чаще всего высокая температура и озноб держатся 2–3 дня, в течение которых токсины покидают организм. При более длительном повышении температуры (1 неделя) следует обратиться к врачу. Жар сопровождает многие формы и степени отравления.
Что делать при температуре после интоксикации у детей
Дети переносят пищевое отравление с температурой тяжелее, чем взрослые. Жар наблюдается на протяжении длительного времени, что представляет угрозу для здоровья. Сбивать температуру рекомендуется только после того, как столбик термометра достигнет отметки в 38,5 °С.
Советы, которые помогают снизить жар у детей после отравления:
- Обтирать ребенка влажным полотенцем или салфеткой, предварительно смоченной в воде с уксусом (в пропорции 1:1). Влажную ткань следует на 2–3 минуты приложить ко лбу.
- В жаропонижающих средствах содержатся разные химические вещества и красители. Врачи рекомендуют использовать ректальные препараты: Парацетамол, Циклоферон, Ибуфен.
- Запрещено применять Анальгин, Аспирин, Амидопирин и др.: средства вызывают сильные побочные реакции у детей.
- Самыми безопасными и действенными жаропонижающими считаются средства в форме сиропа и суспензий, Парацетамол.
- При диарее у ребенка нельзя применять закрепляющие препараты. Это может привести к негативным последствиям, потому как бактерии или токсичные вещества будут накапливаться в организме.
Интоксикация чаще всего сопровождается высокой температурой. Нужно следить за изменениями параметра: показатель не должен превышать 38,5 °C. В противном случае следует вызвать специалиста. Лечащий врач подберет подходящие медикаменты, с помощью которых у ребенка можно добиться снижения температуры.
Что делать, если держится температура после отравления у взрослых
Для выхода вредных элементов и токсинов из организма, вызывающих температуру и недомогание, необходимо использовать комплексные методы. При отсутствии тяжелых хронических заболеваний с возможными рецидивами и сопутствующими осложнениями разрешается осуществлять терапию на дому, которая включает следующие процедуры:
- Лечение активированным углем и другими сорбентами. Продолжительность терапии составляет 7 дней. Параллельно рекомендуется изменить рацион: не употреблять жирные и острые блюда, спиртные напитки.
- Употребление большого количества теплой жидкости. Способствует быстрому выведению ядовитых веществ из организма.
- Прием мочегонных препаратов, один из которых — Фуросемид. Рекомендуется пить отвары лечебных трав и ягод (березовые почки, кукурузные рыльца, шиповник). Вместе с мочой организм покидают токсины и опасные вещества, нагрузка на почки уменьшается.
Если температура не поднимается выше 37 °C, нет необходимости соблюдать постельный режим. Активный двигательный процесс стимулирует усиленное выделение пота — токсичные вещества выводятся через кожные поры. Постоянные занятия спортом, в частности качание пресса, активизируют перистальтику кишечника, что позволяет организму быстро восстановиться после отравления.
Как сбить температуру
Сбивают повышенную температуру лишь в том случае, когда показатель превышает 38 °C. Таблетки — не самый безопасный, но один из наиболее действенных способов быстро снизить жар. Опасность заключается в том, что лекарства нагружают почки и печень, негативно влияют на другие органы.
Медикаментозные средства снимают жар и воспаление. Наиболее эффективные препараты для взрослых:
Обязателен прием сорбентов (Смекта, Сорбекс), которые выводят токсины из организма и нормализуют пищеварительный процесс.
Необходимо периодическое применение клизм (не каждый день) — при частом их использовании происходит вымывание кишечной микрофлоры, что может вызвать сбои в работе ЖКТ. Оптимальное количество процедур составляет 2–3 раза в неделю. Длительность курса — не более 14 дней. Применяют чистую и теплую кипяченую воду или отвар ромашки. Ромашка успокаивает воспалительный процесс, заживляет слизистую оболочку кишечника. Перед началом курса нужно обратиться за консультацией к врачу.
Если интоксикация организма сопровождается частой рвотой, прием пероральных средств не принесет пользы. Сбить жар можно с помощью суппозиториев, растворимых таблеток и порошков:
Если температура тела достигает отметки 39,2 °C, снизить показатель с помощью простых жаропонижающих средств не получится. Необходимо применить внутримышечную инъекцию, состоящую из 2 мл димедрола и такого же количества анальгина.
Чтобы снизить жар при беременности, не следует использовать антибиотики и другие жаропонижающие лекарства: их активные вещества могут вызвать обширное внутреннее кровоизлияние и аномальное развитие плода. Из медикаментов разрешено принимать препараты, в состав которых входит тайленол, парацетамол, панадол.
Если у ребенка высокая температура, следует проветрить помещение, в котором находится дитя, предварительно переведя больного в другое помещение на время проветривания. Пострадавшему необходимо употреблять большой объем теплой жидкости в течение дня. Для снижения жара можно дать парацетамол. Грудничка рекомендуется часто кормить грудью, чтобы в организм младенца поступало больше влаги.
Среди народных средств существует много рецептов, которые помогают справиться с высокой температурой в домашних условиях:
- отвар липы;
- настойка или чай из малиновых листьев;
- компрессы с яблочным уксусом и картофелем;
- протирание столовым уксусом сгибов под коленями и локтями, височной области, лба и шеи.
Для укрепления иммунитета и повышения защитных сил организма следует использовать цитрусовые, добавляя их в чай. Необходимо пить воду с лимонным соком, съедать 2–3 апельсина в неделю (при отсутствии аллергии на фрукты).
Не рекомендуется обтирать тело ребенка уксусным раствором или этиловым спиртом. Ослабленный иммунитет может негативно отреагировать на воздействие, а интоксикация организма усилится.
Читайте также:

микробные — токсикоинфекции, токсикозы;
микробные — токсикоинфекции, токсикозы;